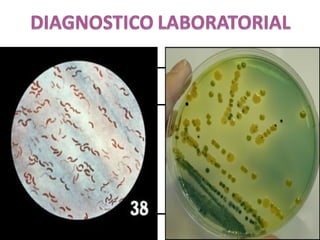
MUESTRA EXAMENDIRECTO CULTIVO
Vómitos
Hecesdiarrecas
BaciloGram
negativosenforma
de“C”o“S”
AgarTCBS

El documento clasifica las bacterias según su forma (cocos o bacilos) y coloración Gram (positiva o negativa). Describe los principales géneros y especies bacterianas, incluyendo Vibrio cholerae, el agente causal del cólera. Explica los síntomas, diagnóstico, tratamiento y prevención de esta enfermedad, destacando la importancia de la hidratación y la desinfección del agua.